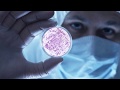
تعرف على بكتيريا الوجه خطورتها أعراضها علاجها

الستات مايعرفوش يكدبوا في نوع من البكتيريا ممكن تصيب الوجه حتى تصل للمخ اعرفوا أسبابها

الحل النهائي السحري لعلاج حبوب الوجه علامة استفهام

بكتيريا الوجه المرض الخطير الذى اصاب ريهام سعيد

مرض بكتيريا الوجه الأسباب والأعراض وطرق العلاج

علاج الفطريات الجلدية في الوجه

الحبوب الفطرية الفرق بينها وبين الحبوب العادية وطرق الوقايه والعلاج

بكتيريا الوجه وأنواعها وطرق علاجها

الستات مايعرفوش يكدبوا في نوع من البكتيريا ممكن تصيب الوجه حتى تصل للمخ اعرفوا أسبابها

بكتيريا الوجه القاتلة التى اصابت ريهام سعيد

بكتيريا الوجه

علاج سحري وفعال لعلاج الحبوب التي تظهر في الوجه علامة استفهام

القوباء العدوى البكتيرية في الجلد اسبابها وعلاجها

ما هي بكتيريا مارسا المكورات العنقودية الذهبية المقاومة للميثيسيلين و العلاج
تعرف على بكتيريا الوجه خطورتها أعراضها علاجها

حب الشباب الفطري مقابل حب الشباب البكتيري كيف تفرق بينهما

بكتيريا الوجه معلومات عن المرض الخطير الذى أصاب ريهاب سعيد

